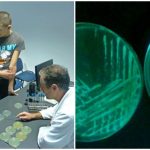

Povodom nadolazeće izložbe Prirodoslovnog muzeja Dubrovnik „Pod pritiskom“ koja će se otvoriti 15. prosinca 2015. organizirane su radionice „Mračna umjetnost“, „Svijeće u morskim dubinama“, „Iglozub“ i „Dubokomorski dijalog“.
U znanstvenoj radionici „Mračna umjetnost“ koja je izvedena u suradnji sa Zavodom za javno zdravstvo Dubrovačko-neretvanske županije, posjetitelji su se upoznali s pojmom bioluminiscencije i pojavom emitiranja svjetla koju posjeduju različite skupine dubokomorskih organizama.
Izolaciju bioluminiscentnih bakterija Vibrio fisheri koja je dobivena s površine kože svježe ulovljenog oslića Merluccius merluccius (Linneaus, 1758) demonstrirao je Paul Bohnert, dr. med., spec. med. mikrobiologije s parazitologijom. Izolirane kolonije bakterija na hranjivoj podlozi proizvodile su intezivno zeleno-plavo svjetlo.
U kreativnoj radionici „Svijeće u morskim dubinama“ sudionici su pomoću tamnog papira i ljepljive fosforiscentne trake izrađivali ribe sa svjetlećim organima – fotoforima.
Radionica „Iglozub“ je izvedena u suradnji sa Ivanom Lujak, akademskom slikaricom i profesoricom likovne kulture u kojoj su posjetitelji prikazali dubokomorsku ribu iglozuba Chauliodus sloani (Bloch i J. G. Schneider, 1801) tehnikom linoreza. Koristeći žljebaste noževe na ploči linoleuma napravili su izdubljeni prikaz koji je korišten za otiskivanje jednostavnih grafičkih uzoraka crteža.
U edukativno – kreativnoj radionici „Dubokomorski dijalog“ zadatak posjetitelja bio je skicirati karikature dubokomorskih riba sa kratkim dijalogom i tako na humorističan način prikazali kako se hrane, bježe od predatora, ili „zavode“u dubokom, mračnom moru.
Radionica je izvedena u suradnji sa restauratorom Robertom Kraljem koji je pojasnio kako se crtaju karikature i na šaljiv način prikazuju skice koje preuveličavaju i deformiraju istaknute osobine pojedinih vrsta riba.
U radionici su sudjelovali učenici Umjetničke škole Luke Sorkočevića Dubrovnik, Gimnazije Dubrovnik, Osnovne škole Župe dubrovačke i Osnovne škole Lapad.